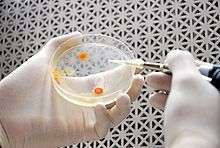

Cupriavidus necator
| Cupriavidus necator | |
|---|---|
| |
| Scientific classification | |
| Domain: | Bacteria |
| Phylum: | Proteobacteria |
| Class: | Betaproteobacteria |
| Order: | Burkholderiales |
| Family: | Ralstoniaceae |
| Genus: | Cupriavidus |
| Species: | C. necator |
| Binomial name | |
| Cupriavidus necator (Davis 1969) Yabuuchi et al. 1996 | |
| Synonyms | |
|
Ralstonia eutropha | |
Cupriavidus necator is a Gram-negative soil bacterium of the Betaproteobacteria class.[1]
Taxonomy
Cupriavidus necator has gone through a series of name changes. In the first half of the 20th century, many micro-organisms were isolated for their ability to use hydrogen. Hydrogen-metabolizing chemolithotrophic organisms were clustered into the group Hydrogenomonas.[2] C. necator was originally named Hydrogenomonas eutrophus because it fell under the Hydrogenomonas classification and was “well nourished and robust”.[3] Some of the original H. eutrophus cultures isolated were by Bovell and Wilde.[4][5] After characterizing cell morphology, metabolism and GC content, the Hydrogenomonas nomenclature was disbanded because it comprised many species of microorganisms.[2] H. eutrophus was then renamed Alcaligenes eutropha because it was a micro-organism with degenerated peritrichous flagellation.[3][6] Investigating phenotype, lipid composition, fatty acid composition and 16S rRNA analysis, A. eutropha was found to belong to the genus Ralstonia and named Ralstonia eutropha.[1] Upon further study of the Ralstonia genus, Ralstonia was found to comprise two phenotypically distinct clusters. The new genus Wautersia was created from one of these clusters which included R. eutropha. In turn R. eutropha was renamed Wautersia eutropha.[7] Looking at DNA-DNA hybridization and phenotype comparison with Cupriavidus necator, W. eutropha was found to be the same species as previously described C. necator. Because C. necator was named in 1987 far before the name change to R. eutropha and W. eutropha, the name C. necator was assigned to R. eutropha according to Rule 23a of the International Code of Nomenclature of Bacteria.[8]
Metabolism
Cupriavidus necator is a hydrogen-oxidizing bacterium (“knallgas” bacterium) capable of growing at the interface of anaerobic and aerobic environments. It can easily adapt between heterotrophic and autotrophic lifestyles. Both organic compounds and hydrogen can be used as a source of energy[9] C. necator can perform aerobic or anaerobic respiration by denitrification of nitrate and/or nitrite to nitrogen gas.[10] When growing under autotrophic conditions, C. necator fixes carbon through the pentose phosphate pathway.[11] It is known to produce and sequester polyhydroxyalkanoate (PHA) plastics when exposed to excess amounts of sugar substrate. PHA can accumulate to levels around 90% of the cell's dry weight.[12] To better characterize the lifestyle of C. necator, the genomes of two strains have been sequenced.[9][13]
Hydrogenases
Cupriavidus necator can use hydrogen gas as a source of energy when growing under autotrophic conditions. It contains three different hydrogenases that have [Ni-Fe] active sites and all perform this reaction:[14]
- H2 2H+ + 2e−
The hydrogenases of C. necator are like other typical [Ni-Fe] hydrogenases because they are made up of a large and a small subunit. The large subunit is where the [Ni-Fe] active site resides and the small subunit is composed of [Fe-S] clusters.[15] However, the hydrogenases of C. necator are different from typical [Ni-Fe] hydrogenases because they are tolerant to oxygen and are not inhibited by CO.[14] While the three hydrogenases perform the same reaction in the cell, each hydrogenase is linked to a different cellular process. The differences between the regulatory hydrogenase, membrane bound hydrogenase, and soluble hydrogeanse in C. necator are described below.
Regulatory hydrogenase
The first hydrogenase is a regulatory hydrogenase (RH) that signals to the cell hydrogen is present. The RH is a protein containing large and small [Ni-Fe] hydrogenase subunits attached to a histidine protein kinase subunit.[16] The hydrogen gas is oxidized at the [Ni-Fe] center in the large subunit and in turn reduces the [Fe-S] clusters in the small subunit. It is unknown whether the electrons are transferred from the [Fe-S] clusters to the protein kinase domain.[14] The histidine protein kinase activates a response regulator. The response regulator is active in the dephosphorylated form. The dephosphorylated response regulator promotes the transcription of the membrane bound hydrogenase and soluble hydrogenase.[17]
Membrane-bound hydrogenase
The membrane-bound hydrogenase (MBH) is linked to the respiratory chain through a specific cytochrome b-related protein in C. necator.[18] Hydrogen gas is oxidized at the [Ni-Fe] active site in the large subunit and the electrons are shuttled through the [Fe-S] clusters in the small subunit to the cytochrome b-like protein.[14] The MBH is located on the outer cytoplasmic membrane. It recovers energy for the cell by funneling electrons into the respiratory chain and by increasing the proton gradient.[18] The MBH in C. necator is not inhibited by CO and is tolerant to oxygen.[19]
Soluble hydrogenase
The soluble hydrogenase (SH) creates a NADH-reducing equivalence by oxidizing hydrogen gas. The SH is a heterodimer protein[20] with two subunits making up the large and small subunits of the [Ni-Fe] hydrogenase and the other two subunits comprising a protein similar to Complex I (as shown in the accompanying figure).[21] The [Ni-Fe] active site oxidized hydrogen gas which transfers electrons to a FMNa cofactor, then to [Fe-S] clusters of the small hydrogenase subunit, then to another FMNb cofactor and finally to NAD+.[14] The reducing equivalence provide a means for fixing carbon dioxide when C. necator is growing autotrophically.[22]
Soluble hydrogenase active site
The active site of the soluble hydrogenase (SH) of C. necator H16 has been extensively studied because C. necator H16 can be produced in large amounts, can be genetically manipulated, and can be analyzed with spectrographic techniques. However, no crystal structure is currently available for the C. necator H16 soluble hydrogenase in the presence of oxygen to determine the interactions of the active site with the rest of the protein.[14]
Typical anaerobic [Ni-Fe] hydrogenases
The [Ni-Fe] hydrogenase from Desulfovibrio vulgaris and D. gigas have similar protein structures to each other and represent typical [Ni-Fe] hydrogenases.[14][23][24][25] The large subunit contains the [Ni-Fe] active site buried deep in the core of the protein and the small subunit contains [Fe-S] clusters. The Ni atom is coordinated to the Desulfovibrio hydrogenase by 4 cysteine ligands. Two of these same cysteine ligands also bridge the Fe of the [Ni-Fe] active site.[23][24] The Fe atom also contains three ligands, one CO and two CN that complete the active site.[26] These additional ligands might contribute to the reactivity or help stabilize the Fe atom in the +2 oxidation state.[23] Typical [NiFe] hydrogenases like those of D. vulgaris and D. gigas are poisoned by oxygen because an oxygen atom binds strongly to the NiFe active site.[19]
C. necator oxygen-tolerant soluble hydrogenase
The soluble [Ni-Fe] hydrogenases in C. necator are unique for other organisms because it is oxygen tolerant.[27] The active site of the SH has been studied to learn why this protein is tolerant to oxygen. A major difference of the [Ni-Fe] hydrogenases of C. necator is it has more coordinating ligands than in typical [Ni-Fe] hydrogenases. Two cysteine ligands bridge the Ni atom and Fe atom of the active site in C. necator. Two modified cysteine sulfenate ligands also are predicted to coordinate the Ni atom.[22] An additional CN ligand is added to the Ni atom and removing this CN ligand makes the enzyme susceptible to oxygen. Also, the Fe has an additional CN ligand bound in addition to the two CN ligands and one CO ligand present in typical NiFe hydrogenases (see the above figure for a schematic of the active site).[28] These additional ligands are predicted to help the protein be more oxygen tolerant because it stabilizes the Ni atom in the active, +2 oxidation state.[22]
Applications
The oxygen-tolerant hydrogenases of C. necator have been studied for diverse purposes. C. necator was studied as an attractive organism to help support life in space. It can fix carbon dioxide as a carbon source, use the urea in urine as a nitrogen source, and use hydrogen as an energy source to create dense cultures that could be used as a source of protein.[29][30]
Electrolysis of water is one way of creating oxygenic atmosphere in space and C. necator was investigated to recycle the hydrogen produced during this process.[31]
Oxygen-tolerant hydrogenases are being used to investigate biofuels. Hydrogenases from C. necator have been used to coat electrode surfaces to create hydrogen fuel cells tolerant to oxygen and carbon monoxide[19] and to design hydrogen-producing light complexes.[32] In addition, the hydrogenases from C. necator have been used to create hydrogen sensors.[33] Genetically modified C. necator can produce isobutanol from CO
2 that can directly substitute or blend with gasoline. The organism emits the isobutanol without having to be destroyed to obtain it.[34]
References
- 1 2 Yabuuchi; et al. (1995). "Transfer of two Burkholderia and an Alcaligenes species to Ralstonia gen. nov.: proposal of Ralstonia pickettii (Ralston, Palleroni and Doudoroff 1973) comb. nov., Ralstonia solanacearum (Smith 1896) comb. nov. and Ralstonia eutropha (Davis 1969) comb. nov". Microbiol Immunol. 39 (11): 897–904. doi:10.1111/j.1348-0421.1995.tb03275.x. PMID 8657018.
- 1 2 Davis, D., Doudoroff, M. and Stanier, R. (1969). "Proposal to reject the genus Hydrogenomonas: Taxonomic implications". Int J Syst Bacteriol. 19 (4): 375–390. doi:10.1099/00207713-19-4-375.
- 1 2 Bowien, B.; Schlegel, H. (1981). "Physiology and biochemistry of aerobic hydrogen-oxidizing bacteria". Annu. Rev. Microbiol. 35: 405–452. doi:10.1146/annurev.mi.35.100181.002201. PMID 6271040.
- ↑ Repaske, R. (1981). "Nutritional Requirements forHydrogenomonas eutropha". J Bacteriol. 83 (2): 418–422. PMC 277745
 . PMID 14491520.
. PMID 14491520. - ↑ Wilde, E. (1962). "Untersuchungen über Wachstum und Speicherstoffsynthese von Hydrogenomonas eutropha". Archiv für Mikrobiologie. 43: 109–137. doi:10.1007/bf00406429.
- ↑ Davis, D., Stanier, R. and Doudoroff, M. (1970). "Taxonomic Studies on Some Gram Negative Polarly Flagellated "Hydrogen Bacteria" and Related Species". Arch. Mikrobiol. 70 (1): 1–13. doi:10.1007/BF00691056. PMID 4987616.
- ↑ Vaneechoutte, M., Kampfer, P., De Baere, T., Falsen, E. and Verschraegen, G. (2004). "Wautersia gen. nov., a novel genus accommodating the phylogenetic lineage including Ralstonia eutropha and related species, and proposal of Ralstonia [Pseudomonas] syzygii(Roberts et al. 1990) comb. nov". International Journal of Systematic and Evolutionary Microbiology. 54 (Pt 2): 317–327. doi:10.1099/ijs.0.02754-0. PMID 15023939.
- ↑ Vandamme, P.; Coenye, T. (2004). "Taxonomy of the genus Cupriavidus: a tale of lost and found". International Journal of Systematic and Evolutionary Microbiology. 54 (6): 2285–2289. doi:10.1099/ijs.0.63247-0. PMID 15545472.
- 1 2 Pohlmann, A., Fricke, W., Reinecke, F., Kusian, B., Liesegang, H., Cramm, R., Eitinger, T., Ewering, C., Potter, M., Schwartz, E., Strittmatter, A., Vob, I., Gottschalk, G., Steinbuchel, A., Friedrich, B. and Bowien, B. (2006). "Genome sequence of the bioplastic-producing Knallgas bacterium Ralstonia eutropha H16". Nature Biotechnology. 24 (10): 1257–1262. doi:10.1038/nbt1244. PMID 16964242.
- ↑ Cramm, R. (2009). "Genomic View of Energy Metabolism in Ralstonia eutropha H16". J Mol Microbiol Biotechnol. 16 (1–2): 38–52. doi:10.1159/000142893. PMID 18957861.
- ↑ Bowien, B.; Kusian, B. (2002). "Genetics and control of CO2 assimilation in the chemoautotroph Ralstonia eutropha". Arch Microbiol. 178 (2): 85–93. doi:10.1007/s00203-002-0441-3. PMID 12115053.
- ↑ Spiekermann, P.; Rehm, B.; Kalscheuer, R.; Baumeister, D. & Steinbuchel A. (1999). "A sensitive, viable-colony staining method using Nile red for direct screening of bacteria that accumulate polyhydroxyalkanoic acids and other lipid storage compounds". Arch Microbiol. 171 (2): 73–80. doi:10.1007/s002030050681. PMID 9914303.
- ↑ Lykidis, A., Perez-Pantoja, D., Ledger, T., Marvomatis, K., Anderson, I., Ivanova, N., Hooper, S., Lapidus, A., Lucas, A., Gonzalez, B. and Kyrpides, N. (2010). Ahmed, Niyaz, ed. "The Complete Multipartite Genome Sequence of Cupriavidus necator JMP134, a Versatile Pollutant Degrader". PLOS. 5 (3): 1–13. doi:10.1371/journal.pone.0009729. PMC 2842291
 . PMID 20339589.
. PMID 20339589. - 1 2 3 4 5 6 7 Burgdorf, T., Buhrke, T., van der Linden, E., Jones, A., Albracht, S. and Friedrich, B. (2005). "[NiFe]-Hydrogenases of Ralstonia eutropha H16: Modular Enzymes for Oxygen-Tolerant Biological Hydrogen Oxidation". J Mol Microbiol Biotechnol. 10 (2–4): 181–196. doi:10.1159/000091564. PMID 16645314.
- ↑ Schwartz, E.; Friedrich, B. (2006). "The H2-Metabolizing Prokaryotes". Prokaryotes. 2: 496–563. doi:10.1007/0-387-30742-7_17.
- ↑ Lenz, O.; Friedrich, B. (1998). "A novel multicomponent regulatory system mediates H2 sensing in Alcaligenes eutrophus". PNAS. 95 (21): 12474–12479. doi:10.1073/pnas.95.21.12474. PMC 22855
 . PMID 9770510.
. PMID 9770510. - ↑ Friedrich, B., Buhrke, T. and Burgdorf, T. (2005). "A hydrogen-sensing multiprotein complexcontrols aerobic hydrogen metabolism in Ralstonia eutropha". Biochemical Society Transactions. 33 (Pt 1): 97–101. doi:10.1042/BST0330097. PMID 15667276.
- 1 2 Bernhard, M., Benelli, B., Hochkoeppler, A., Zannoni, D. and Friedrich, B. (1997). "Functional and structural role of the cytochrome b subunit of the membrane-bound hydrogenase complex of Alcaligenes eutrophus H16". Eur. J. Biochem. 248 (1): 179–186. doi:10.1111/j.1432-1033.1997.00179.x. PMID 9310376.
- 1 2 3 Vincent, K., Cracknell, J., Lenz, O., Zebger, I., Friedrich, B. and Armstrong, F. (2005). "Electrocatalytic hydrogen oxidation by an enzyme at high carbon monoxide or oxygen levels". PNAS. 102 (47): 16951–16954. doi:10.1073/pnas.0504499102. PMC 1287975
 . PMID 16260746.
. PMID 16260746. - ↑ Schneider, K.; Schlegel, H. (1976). "PURIFICATION AND PROPERTIES OF SOLUBLE HYDROGENASE FROM ALCALIGENES EUTROPHUS H 16". Biochimica et Biophysica Acta. 452: 66–80. doi:10.1016/0005-2744(76)90058-9. PMID 186126.
- ↑ Tran-Betcke, A., Warnecke, U., Bocker, C., Zaborosch, C. and Friedrich, B. (1990). "Cloning and Nucleotide Sequences of the Genes for the Subunits of NAD-Reducing Hydrogenase of Alcaligenes eutrophus H16". Journal of Bacteriology. 172 (6): 2920–2929. PMC 209089
 . PMID 2188945.
. PMID 2188945. - 1 2 3 Burgdorf, T., Loscher, S., Liebisch, P., Van der Linden, E., Galander, M., Lendzian, F., Meyer-Klaucke, W., Albracht, S., Friedrich, B., Dau, H. and Haumann, M. (2005). "Structural and Oxidation-State Changes at Its Nonstandard Ni-Fe Site during Activation of the NAD-Reducing Hydrogenase from Ralstonia eutropha Detected by X-ray Absorption, EPR, and FTIR Spectroscopy". JACS. 127 (2): 576–592. doi:10.1021/ja0461926. PMID 15643882.
- 1 2 3 Higuchi, ., Yagi, T. and Yasuoka, N. (1997). "Unusual ligand structure in Ni–Fe active center and an additional Mg site in hydrogenase revealed by high resolution X-ray structure analysis". Structure. 5 (12): 1671–1680. doi:10.1016/S0969-2126(97)00313-4. PMID 9438867.
- 1 2 Volbeda, A., Garcin, E., Piras, C., de Lacey, A., Fernandez, V., Hatchikian, C., Frey, M. and Fontecilla-Camps, J. (1996). "Structure of the [NiFe] Hydrogenase Active Site: Evidence for Biologically Uncommon Fe Ligands". J. Am. Chem. Soc. 118 (51): 12989–12996. doi:10.1021/ja962270g.
- ↑ Volbeda, A., Charon, M., Piras, C., Hatchikian, C., Frey, M. and Fontecilla-Camps, J. (1995). "Crystal structure of the nickel-iron hydrogenase from Desulfovibrio gigas". Nature. 373 (6515): 580–587. doi:10.1038/373580a0. PMID 7854413.
- ↑ Happe, R., Roseboom, W., Pierik, A. and Albracht, S. (1997). "Biological activation of hydrogen". Nature. 385 (6612): 126. doi:10.1038/385126a0.
- ↑ Schneider, K., Cammack, R., Schlegel, G. and Hall, D. (1979). "THE IRON-SULPHUR CENTRES OF SOLUBLE HYDROGENASE FROM ALCALIGENES EUTROPHUS". Biochimica et Biophysica Acta. 578 (2): 445–461. doi:10.1016/0005-2795(79)90175-2. PMID 226163.
- ↑ Happe, R., Roseboom, W., Egert, G., Friedrich, C., Massanz, C., Friedrich, B. and Albracht, S. (2000). "Unusual FTIR and EPR properties of the H2-activating site of the cytoplasmic NAD-reducing hydrogenase from Ralstonia eutropha". FEBS. 466 (2–3): 259–263. doi:10.1016/S0014-5793(99)01799-8. PMID 10682839.
- ↑ Repaske, R.; Mayer, R. (1976). "Dense Autotrophic Cultures of Alcaligenes eutrophus". Applied and Environmental Microbiology. 32 (4): 592–597. PMC 170312
 . PMID 10840.
. PMID 10840. - ↑ Ammann, E.; Reed, L. (1967). "METABOLISM OF NITROGEN COMPOUNDS BY HYDROGENOMONAS EUTROPHA". Biochim. Biophys. Acta. 141 (1): 135–143. doi:10.1016/0304-4165(67)90252-8. PMID 4963807.
- ↑ Foster, J.; Litchfield, J. (1964). "A Continuous Culture Apparatus for the Microbial Utilization of Hydrogen Produced by Electrolysis of Water in Closed-Cycle Space Systems". Biotechnology and Bioengineering. 6 (4): 441–456. doi:10.1002/bit.260060406.
- ↑ Ihara, M., Mishihara, H., Yoon, K., Lenz, O., Friedrich, B., Nakamoto, H., Kojima, K., Honoma, D., Kamachi, T. and Okura, I. (2006). "Light-driven Hydrogen Production by a Hybrid Complex of a [NiFe]-Hydrogenase and the Cyanobacterial Photosystem I". Photochemistry and Photobiology. 82 (3): 676–682. doi:10.1562/2006-01-16-RA-778. PMID 16542111.
- ↑ Lutz, B., Fan, H., Burgdorf, T. and Friedrich, B. (2005). "Hydrogen Sensing by Enzyme-Catalyzed Electrochemical Detection". Anal. Chem. 77 (15): 4969–4975. doi:10.1021/ac050313i. PMID 16053311.
- ↑ "Teaching a microbe to make fuel - MIT News Office". Web.mit.edu. Retrieved 2012-08-22.